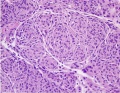
Thumbnail for version as of 16:02, November 2, 2013

File:Figure 1 SWM.jpg
From EyeWiki
Figure_1_SWM.jpg (625 × 484 pixels, file size: 129 KB, MIME type: image/jpeg)
FIGURE 1: Sphenoid wing meningioma (H&E, 20x). Image depicts whorls of meningothelial cells composed of bland epithelioid type cells with eosinophilic cytoplasm arranged in a syncitium. The nuclei are ovoid with vacuoles and pseudo-inclusions.
File history
Click on a date/time to view the file as it appeared at that time.
| Date/Time | Thumbnail | Dimensions | User | Comment | |
|---|---|---|---|---|---|
| current | 16:02, November 2, 2013 | | 625 × 484 (129 KB) | Kenneth.M.Downes (talk | contribs) | |
| 15:29, November 2, 2013 |  | 800 × 488 (83 KB) | Kenneth.M.Downes (talk | contribs) | FIGURE 1: Sphenoid wing meningioma (H&E, 20x). Image depicts whorls of meningothelial cells composed of bland epithelioid type cells with eosinophilic cytoplasm arranged in a syncitium. The nuclei are ovoid with vacuoles and pseudo-inclusions. |
You cannot overwrite this file.
File usage
The following page uses this file:


